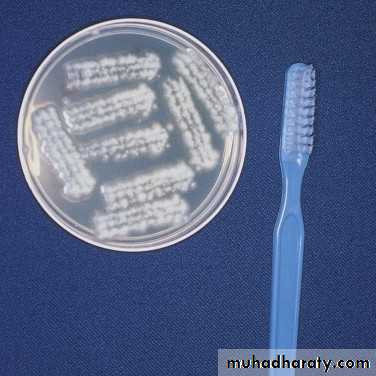

Superficial Fungal Infections
Omar Y. AbdullahClinical Dermatology MSc
London, UK
Dermatophyte fungal infections
Dermatophytes are a group of fungi (ringworm) that only infect and survive on the stratum corneum, hair, and nails (dead keratin).Cannot survive on mucosal surfaces where keratin does not form.
Very rarely, dermatophytes undergo deep local invasion and multivisceral dissemination in the immunosuppressed.
Genetic susceptibility may predispose to dermatophyte infection.
The ringworm fungi belong to three genera: Microsporum, Trichophyton, and Epidermophyton.
Anthropophilic dermatophytes like Trichophyton ruburm, T. tonsurans, T. violaceum and Microsporum audouinii
Zoophilic dermatophytes like M. canis and T. verrucosum
Geophilic dermatophytes like M. gypseum
In general, zoophilic and geophilic dermatophytes elicit a severe inflammatory responses VS the anthropophilc ones.
The active border
One very characteristic pattern of inflammation is the active border of infection.
The highest numbers of hyphae are located in the active border, so samples are taken from here.
Typically the active border is scaly, red, and slightly elevated.
Vesicles appear at the active border when inflammation is intense.
This pattern is present in all locations except the palms and soles.
Tinea of the foot (tinea pedis, athlete’s foot)
The feet are the most common area infected by dermatophytes?Trichophyton rubrum is the usual pathogen.
Usually associated with fungal toenail infection.
Itching is variable in the four clinical types.
1. The classic “ringworm” pattern
2. Interdigital tinea pedis (toe web infection)The web between the fourth and fifth toes is most commonly involved.
Tight-fitting shoes are a predisposing factor.
The toe web can become dry, scaly, and fissured or white, macerated, and wet.
The bacterial flora is unchanged in the dry scaly pattern.
The macerated pattern occurs from an interaction of bacteria and fungus.
Extension out of the web space onto the sole or dorsum of the foot is common.
3. Chronic scaly infection of the plantar surface
Plantar hyperkeratotic or moccasin-type tinea pedis is a particularly chronic form of tinea that is resistant to treatment.
Clinically…
The hands may be similarly infected (two feet-one hand syndrome).
• Acute vesicular tinea pedis
A highly inflammatory fungal infection.Occlusive shoes predispose to it.
It often originates from a more chronic web infection.
A few or many vesicles evolve rapidly on the sole or on the dorsum of the foot.
Specimens for KOH examination are taken from where?
Treatment
Terbinafine 1% cream twice daily for 1 week in the interdigital type.Econazole is excellent in the macerated interdigital TP.
Recurrence is prevented by wearing wider shoes and expanding the web space with a small strand of lamb’s wool. Powders(not necessarily medicated) absorb moisture.
Oral terbinafine 250 mg daily for 2 weeks in the hyperkeratotic type and other types of TP.
Acute vesicular tinea pedis responds to wet compresses, oral antifungal and oral antibiotics.
Id reaction requires wet dressings, group V topical steroids, and occasionally systemic steroids.
Tinea of the groin
Tinea of the groin (tinea cruris) occurs in the summer as well as in the winter.
Warm, moist environment.
Men > women; children rarely develop tinea cruris.
The lesions are most often unilateral (unlike candida) and begin in the crural fold.
Clinically…
The infection occasionally migrates to the buttock and gluteal cleft area.
Involvement of the scrotum is unusual (unlike candida).
DDx: intertrigo, erythrasma, inverse psoriasis, seborrheic dermatitis and candidaisis.
Treatment…
Tinea of the body and face
Tinea of the face (excluding the beard area in men), trunk, and limbs is called tinea corporis.There is a broad range of manifestations, with lesions varying in size, degree of inflammation, and depth of involvement due to differences in host immunity and the species of fungus.
Clinically…
Deep inflamatory lesions are caused by zoophilic fungi.
Treatment…
Tinea of the hand
Tinea of the dorsal aspect of the hand (tinea manuum) has all of the features of tinea corporis.Tinea of the palm has the same appearance as the dry, diffuse, keratotic form of tinea of the sole.
The dry keratotic form may be asymptomatic.
Tinea of the palms is frequently seen in association with tinea pedis (pattern).
Fingernail infection often accompanies tinea manuum.
Treatment…
Tinea incognito
Fungal infections treated with topical steroids often lose some (or sometimes all) of their characteristics.Tinea of the hand, body, face and groin are often misdiagnosed as eczema and treated with topical steroids.
Topical steroids reduce inflammation giving false impression of improvement.
In the mean time, the fungus flourishes. Why?
Treatment is stopped, the rash returns, but by this time it has changed. How?
Intensity of itching is variable.
Hyphae are easily seen with KOH exam. several days after stopping the use of steroids when scaling reappears.
Tinea of the scalp
Tinea capitis occurs most frequently in prepubertal children.The causative species vary from country to country, but anthropophilic species predominate in most areas.
It is most common in areas of poverty and crowded living conditions.
Unlike other fungal infections, tinea capitis may be contagious by direct contact and as well as contaminated clothing or wear; therefore close contact is not necessary for transmission and isolation is justified.
Asymptomatic scalp carriage of dermatophytes can occur and may continue indefinitely.
Patterns of invasion
ENDOTHRIX PATTERN OF INVASIONEndothrix hair invasion is produced predominantly by T. tonsurans, T. soudanense, and T. violaceum.
The fungus grows completely within the hair shaft, and the cuticle surface of the hair remains.
Endothrix infections tend to progress, become chronic, and may last into adult life.
ECTOTHRIX PATTERN OF INVASION
Ectothrix hair invasion is associated with M. audouinii, M. canis, and T. verrucosum.
The hyphae break through the surface of the hair shaft (cuticle) and form a sheath.
Therefore, spores are located inside and outside the hair shaft.
Clinical infection patterns
There may be multiple cases within a family, and each person may have a different infection pattern which may be due to specific host T-lymphocyte response.• Noninflammatory grey patch pattern
2. Noninflammatory black dot pattern
Lack of inflammation may be explained by the fact that
cell-mediated immunity to Trichophyton antigen skin tests
is negative in these patients.
Clinically…
DDx: Alopecia areata, trichotillomania.
3. Inflammatory tinea capitis (kerion)
Most patients have a positive skin test to the Trichophyton antigen, suggesting that the patient’s immune response may be responsible for intense inflammation.Clinically…
Lymphadenopathy
DDx: Abscess, neoplasm.
KOH mounts and fungal cultures are often negative because of destruction of fungal structures by inflammation.
Scarring alopecia may occur.
4. Seborrheic dermatitis type
This type is the most difficult to diagnosis because it resembles dandruff.Clinically…
DDx: Psoriasis, atopic and seborrheic dermatitis.
5. Pustular type
Follicular pustules may be sparse or numerous.No scale or significant hair loss (slight).
Lymphadenopathy
DDx: Bacterial folliculitis, dissecting folliculitis.
Cultures and KOH wet mounts may be negative.
Investigations
Collection of samples (brush)KOH
Culture
Wood’s lamp: Blue-green fluorescence of hair—only M. canis and M. audouinii have this feature. Scale and skin do not fluoresce.
Treatment of tinea capitis
Topical antifungals are not recommended and not effective.Systemic therapy is the sole treatment.
Griseofulvin
Is the current drug of choice in children (safe, least known drug interactions, well tolerated, suspension form).
It is fungistatic and antiinflammatory.
Dose: 15-25 mg/kg/day.
Fatty foods enhance absorption.
Prolonged treatment required (2-3 months).
Side effects: GI upset, headache, dizziness, insomnia, cutaneous eruptions, photosensitivity.
Contraindications…
Trebinafine
Fungicidal.Dose: 125-250 mg/day for 4 weeks.
Food enhances absorption by 20%.
Side effects: GI upset, alteration in taste, cutaneous eruptions, neutropenia, agranulocytosis, abnormal LFTs (3.5-7%).
No suspension formulation.
Itraconazole
Additional measures
Shaving the headExclusion from school
Familial screening (including pets)
Dealing with carriers
Cleansing of fomites
Steroids: The use of corticosteroids (both oral and topical) for inflammatory varieties (e.g., kerions and severe id reactions) is controversial, but may help to reduce itching and general discomfort.
Tinea of the beard
Tinea barbae is a dermatophytic infection confined to the coarse hair-bearing beard and mustache areas in men.Usually occurs after minor trauma such as shaving.
Like tinea capitis, the hairs are almost always infected and easily removed.
Hairs in bacterial folliculitis resist removal.
Superficial follicular infection, resembles the annular tinea corporis.
Deep follicular infection, resembles bacterial folliculitis but evolves slowly and is usually restricted to one area of the beard.
Bacterial folliculitis spreads rapidly over wide areas after shaving.
Zoophilic T. mentagrophytes and T. verrucosum are the most common pathogens.
Treatment: same as tinea capitis, oral agents are required.
Onychomycosis
Onychomycosis is a fungal infection of the nail plate and/or nail bed.It accounts for about 50% of all nail diseases and approximately 30% of all superficial fungal infections.
The worldwide prevalence is high and increasing.
Onychomycosis is a significant medical disorder and can lead to serious complications in certain patients such as diabetics.
Both sexes and all age groups are affected.
The affected patients (1) harbour a fungal reservoir and have the potential to infect other individuals, (2) are physically and psychologically (especially females) impaired by the diseased nails, and (3) suffer a financial burden from repeated medical consultations and medication costs.
Dermatophytes, yeasts and moulds can cause onychomycosis.
Risk factors for onychomycosis
Advanced age
Associated tinea pedisImmunodeficiency states
Diabetes Mellitus
Peripheral vascular disease
Occlusive footwear
Sports activities
Repeated nail trauma
Impaired foot and nail hygiene
Genetic predisposition
Chronic smoking
Occupational risk (housewives, athelets)
Clinical patterns of infection
1. Distal and lateral subungual onychomycosis:Is the most common pattern.
The distal parts of the nail plate to turn yellow, brown or black, usually close to the lateral nail fold.
Subungual hyperkeratosis and onycholysis.
The infection can progress proximally forming linear channels which are highly characteristic of onychomycosis.
Typically caused by T. rubrum.
2. Superficial white onychomycosis:
This less common but interesting pattern is due to fungal invasion of the dorsal (outer) layer of the nail plate.It typically presents as well-demarkated powdery white patches or striate bands that can easily be scraped away.
The nail plate is often not thickened nor elevated from the underlying nail bed.
T. mentagrophytes var. interdigitale is the most common pathogen.
3. Proximal subungual onychomycosis:
Is common in AIDS patients.
It is considered as one of the early markers of HIV infection. The fungus gains entry to the nail through the proximal nail fold and then extends.
The surface remains intact.
Transverse white patches form at the proximal nail fold and move outwards as the nail plate grows.
The nail plate is marginally thickened and onycholysis may develop.
The main agents associated are T. rubrum and less commonly C. albicans.
4. Endonyx:
Here the fungus invades the entire thickness of the nail plate.The nail bed is spared.
Milky-white patches together with scarring, coarse pitting and lamellar peeling.
Nail thickening, separation and inflammatory changes are not seen.
Mainly caused by T. soudanense, T. violaceum and T. tonsurans.
5. Total dystrophic onychomycosis (TDO):
Two subtypes of TDO are identified:
• The first occurs in the setting of chronic mucocutaneous candidosis.
• The second TDO represents the end result of any kind of longstanding untreated onychomycosis.
There is almost complete destruction of the nail plate.
Candidal Onychomycosis
Four patterns of candidal onychomycosis have been identified1. Candidal paronychia with secondary nail dystrophy
• Distal nail infection
• Chronic mucocutaneous candidosis
• Secondary candidiasis
There are two major types of paronychia
1. Acute paronychia which is mostly caused by bacteria.
2. Chronic paronychia which is often associated with Candida.
Chronic paronychia occurs in individuals excessively exposed to moisture and detergents.
Typically, many or all fingernails are affected at the same time.
The nail folds become inflamed and the cuticle detaches from the nail plate losing its water-proof properties.
Yeasts get entry into the sub-cuticular area causing more inflammation and more cuticular detachment.
Once the nail matrix is involved, horizontal ridges (Beau's lines) appear and the nail plate becomes irregular, thickened, and convex, and if untreated nail dystrophy may be the end result.
1 2 3
Diagnosis
Because many other nail ailments can mimic onychomycosis and due to the costly and potentially harmful oral medications, it is crucial to obtain mycological confirmation before commencing therapy.KOH microscopy (bright-field illumination and calcofluor white)
Culture?
Histopathology?
Treatment
Current medications are often ineffective in the long-term management and are often associated with high relapse? and re-infection? rates (recurrence=40%-70%). Prognosis?Patient compliance is critical to achieving therapeutic success.
Terbinafine is the single most efficacious and cost-effective agent at a single 250 mg daily dose for 3 months.
Itraconazole and fluconazole are more effective than terbinafine against Candida.
Oral antifungals may not be suitable for certain patients?
Topical antifungals (amorolfine 5% and cicolpirox olamine 8%) are only effective for treating early and mild disease.
Combination therapy is the best approach.
Topical agents should also be used as a long-term prophylaxis to prevent recurrence after successful oral therapy.
Ketoconazole and griseofulvin?
Nail removal.
Candidiasis
The yeastlike fungus C. albicans and a few other Candida species are capable of producing skin, mucous membrane, and internal infections.
It is part of the normal flora of the mouth, vaginal tract, and gut.
The yeast may become pathogenic in certain circumstances like?
Candidal pseudohyphae and hyphae can be indistinguishable from dermatophytes in KOH exam..
Culture results must be interpreted carefully. Why?
The yeast infects only the outer layers of the epithelium of mucous membranes and skin.
The primary lesion is a pustule, the contents of which dissect horizontally under the stratum corneum and peel it away.The infection is confined to the mucous membranes and intertriginous areas. Why?
Candidiasis of large skin folds
Candidiasis of large skin folds (Candida intertrigo) occurs under pendulous breasts, between overhanging abdominal folds, in the groin and rectal area, and in the axillae.Skin folds (intertriginous areas where skin touches skin) contain heat and moisture.
There are two clinical presentations: 1.macerated pustules that extend beyond the skin fold borders; and 2.red moist glistening plaque.
Rx?
Diaper Candidiasis
An artificial intertriginous area is created under a wet diaper, predisposing the area to a yeast infection with the characteristic red base and satellite pustules.Rx:
Dryness should be maintained. How?
Antifungal creams twice a day for approximately 10 days.
Residual erythema from irritation may be present after 10 days. What to do?
Mupirocin ointment 2% is effective for severe Candida and bacterial diaper dermatitis.
DDx:
Candidiasis of small skin folds
1. FINGER AND TOE WEBSWeb spaces are like small intertriginous areas.
Those who work in a moist environment are at risk.It may coexist with dermatophytes and gram-negative bacteria.
Clinically and in potassium hydroxide preparations, infection by Candida and dermatophytes may appear to be identical.
2. ANGLES OF THE MOUTH
Angular cheilitis (inflammation at the angles of the mouth) can occur at any age.Yeasts and/or bacteria may be involved in the process.
Continued irritation by the presence of saliva at the mouth angles leads to eczematous inflammation.
Lip licking, biting the corners of the mouth, or thumb sucking causes cheilitis in the young.
In older patients: advancing age, mouth breathing secondary to nasal congestion, malocclusion resulting from poorly fitting dentures, compulsive lip licking and aggressive use of dental floss may cause mechanical trauma to mouth angles.
The infection starts as a sore fissure in the depth of the skin fold. Erythema, scale, and crust form at the sides of the fold.
Rx:
Antifungal creams, followed in a few hours by a group V steroid creams until the area is dry and free of inflammation.
Thereafter, a thick, protective lip balm is applied frequently.
Mupirocin ointment or cream 2%.
Cosmetic fillers injected at the mouth angles.
Tinea Versicolor
Tinea versicolor is a common fungal infection of the skin caused by the dimorphic lipophilic yeasts Pityrosporum orbiculare (round form) and Pityrosporum ovale (oval form).The organism is part of the normal skin flora and is concentrated in areas with (and years of) increased sebaceous activity.
It resides within the stratum corneum and hair follicles.
Certain predisposing endogenous factors or exogenous factors?
Some individuals, especially those with oily skin, may be more susceptible.
Is it contagious? Not known.
Clinically
Lesions begin as multiple small, circular macules of various colors (pink, white, or brown) that enlarge radially.A spectrum of clinical presentations and colors:
• Red to fawn-colored macules, patches, or follicular papules
• Hypopigmented lesions.
• Tan to dark brown macules and patches.
However, the color is uniform in each individual.
Distribution?
Symptoms
DDx: Vitiligo, pityriasis alba, seborrheic dermatitis, secondary syphilis, and pityriasis rosea.
Investigations
Scraping & KOH: spaghetti-and-meatballs pattern.
Wood’s light examination shows irregular, pale, yellow-to-white fluorescence.
Treatment
Topical treatment is indicated for limited disease & recurrence rates are high.Ketoconazole shampoo 2%.
Selenium sulfide suspension 2.5%.
Terbinafine spray 1%.
Other topical antifungals.
Oral itraconazole and fluconazole (extensive disease and multiple recurrences).
Oral terbinafine and griseofulvin? Ineffective.